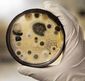

Suite aux inondations, les murs mettent du temps à sécher et deviennent des milieux excessivement favorables au développement des moisissures.
Dans la mesure du possible, il faut les gérer au plus vite pour réduire le risque sanitaire associé à la présence de ces champignons.
La Région wallonne a résumé les conseils à suivre pour réduire le risque d’exposition.
Site de l’Agence pour une Vie de Qualité - Nombreuses fiches à télécharger !
Inondations
Cellule Permanente Environnement Santé (CPES) - (...)